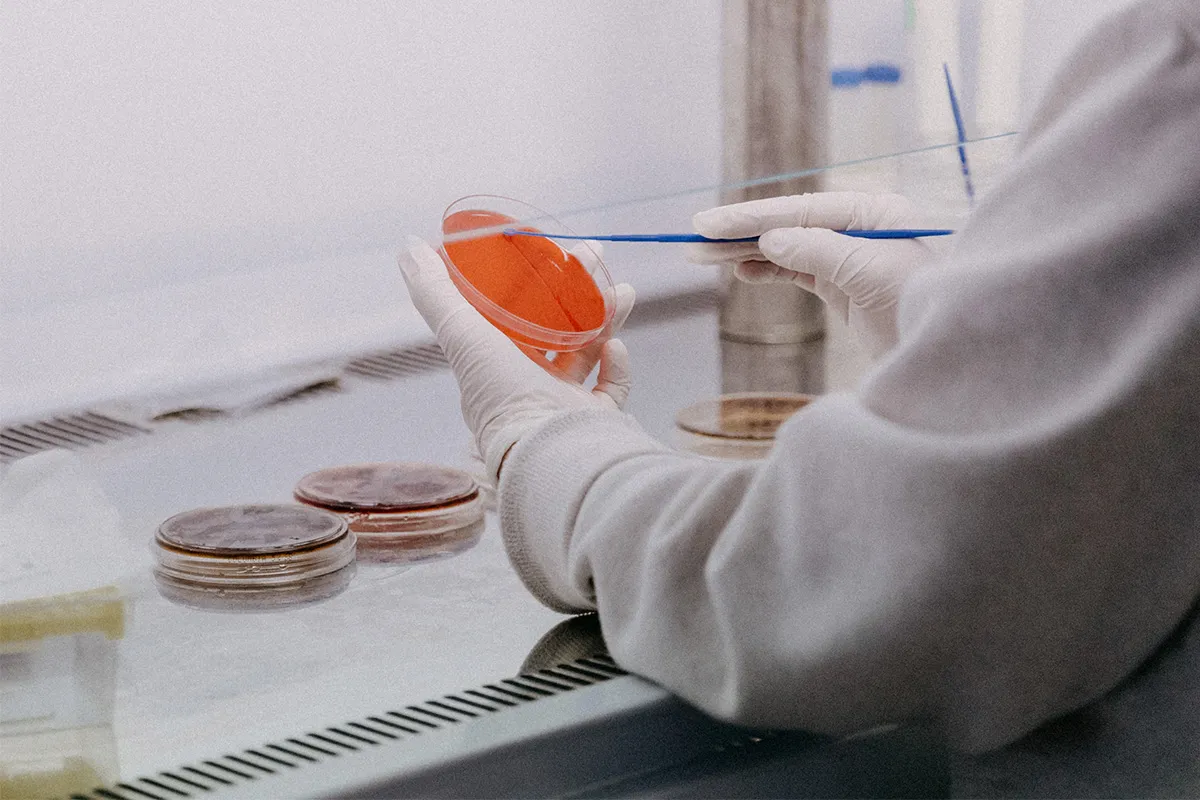

«Ради победы надо смотреть в глаза монстру»: снова об очагах планетарных угроз
- 01 февраля 2023 04:39
- Александр Александровский, Политолог
«Ридус» с момента начала всемирной пандемии регулярно поднимает вопрос биологических угроз. Между тем на фоне потрясений последнего времени расширяются и география этой темы, и сама проблематика, обрастающая смежными секторами и направлениями.
Мы много раз апеллировали к Конвенции о запрещении разработки, производства и накопления запасов бактериологического (биологического) и токсинного оружия и об их уничтожении (КБТО). Но недавние события показали, что актуальной становится и Конвенция о запрещении химического оружия.
Нашумевшее видео, на котором украинские военные под Артемовском кичатся тем, что готовятся использовать БПЛА с некими цилиндрическими боеприпасами (видимо, содержащими химические вещества), снято нацистом с позывным «Мадьяр». Он часто появляется в эфире украинских каналов. В том, что тактическая группа «Птицы Мадьяра» способна применить химическое оружие, сомневаться не приходится.
Ранее бойцы ЧВК «Вагнер» уже сообщали об использовании украинским военными под Артемовском синильной кислоты.
Можно предположить, что по мере освобождения населенных пунктов Донбасса мы еще узнаем шокирующие подробности преступной деятельности украинских военных, получим свидетельства нарушений ими законов или обычаев войны.
Недавно Центр расследований Василия Прозорова на ресурсе UKR LEAKS сообщил о том, что в Лисичанске нашли биоматериалы испытуемых печально известной биолабораторией «Фармбиотест» в Рубежном.
Об этой биолаборатории и раньше рассказывал Василий Прозоров: «Во время моей командировки на Донбасс я узнал от местных жителей, что в городе Рубежное в здании компании «Фармбиотест» над людьми проводились опыты. Я сразу же отправился туда. То, что я там увидел и услышал, меня шокировало. В это здание приходили местные жители, которым за денежное вознаграждение вкалывали неизвестные препараты. Размер финансово вознаграждения зависел от степени опасности вводимого вещества. После инъекции за пациентами наблюдали врачи из специального помещения. По сути, люди использовались как подопытные животные. Зачастую, препараты тестировались в ускоренном режиме без соблюдения соответствующих норм и правил». По информации UKR LEAKS, в ряде случаев испытания заканчивались смертью пациентов. Чем опаснее было вещество, тем больше платили подопытным.
«И вот, документы и биоматериалы этой лаборатории обнаружились на городском кладбище в Лисичанске, — сообщил В. Прозоров. — Кто и зачем попытался скрыть анализы и медицинские карты испытуемых будут выяснять следователи. Но сам факт, что кто-то с украинской стороны решил замести следы и закопал эти материалы, уже вызывает ряд вопросов». Создатель UKR LEAKS утверждает, что лаборатория работала в интересах стран Европы и США, чем и объясняется попытка сокрытия улик.
В. Прозоров обстоятельно занимается проблемой биологических угроз — не только в украинском контексте. В своем недавнем интервью с украинско-чилийским журналистом Олегом Ясинским он задал вопрос о деятельности американских военно-биологических лабораторий и корпораций на территории Латинской Америки. Ясинский ответил, что эта тема гиперсекретна в Латинской Америке. Но акцентировал внимание на проникновении международных фармацевтических концернов, которые наверняка очень тесно связаны, как близнецы братья, с биолабораториями.

Олег Ясинский рассказал UKR LEAKS:
«У индейских народов Латинской Америки в амазонской сельве есть огромные знания о растениях. Ни одна травка, ни одно растение не растет просто так. У них ценнейшие, важнейшие свойства. И очень многие агенты лабораторий — это те же агенты западных фармацевтических спецслужб — под видом учёных попадают в сельву, в индейские общины, получают информацию обо всем этом, чтобы потом пришла какая-нибудь «Монсанто», подписала контракт с правительством и запатентовала то или иное растение, то или иное его свойство, начиная потом с биоразрушения региона. Мы знаем генетически изменённые продукты. Мы знаем, как крестьян в Мексике, в Колумбии лишили их прав выращивать кукурузу, как выращивали их предки…»
Журналист подчеркивает, что всё это происходило благодаря деятельности транснациональной компании «Монсанто».
«Для того чтоб крестьянин остался в рынке, он должен купить лицензию, он должен покупать семена на свой бывший продукт модифицированный уже через «Монсанто», — объясняет О. Ясинский. — У крестьянина нет на это денег, он не выдерживает конкуренцию, разоряется».
По словам журналиста, единственный кто может дать ссуду крестьянину — наркотрафиканты, которым он возвращает продуктами.
«Это страшная организация, потому что больших коррупционных скандалов, чем с «Монсанто», у Латинской Америки не было, — продолжает Ясинский. — Она просто привыкла подкупать власти стран третьего мира. Причем подкупаются как правореакционные правительства, так и левопрогрессивные тоже. Это огромная проблема. И тема «Монсанто» — это табу. Пресса не любит говорить на эту тему. В свое время на Украине тоже невозможно было говорить о «Монсанто». То же самое сейчас происходит в Латинской Америке . О «Монсанто» мы можем говорит только в какой-то периферийной, изгойной левой независимой прессе, которую читают только те, кто ищут альтернативную информацию».
Прозоров поинтересовался, является ли «Монсанто» надгосударственной надстройкой. Собеседник отвечает, что «Монсанто», как и наркотрафик, как и множество подобных организаций, намного сильнее большинства местных государств: «Они решают. Государственные чиновники являются их региональными управляющими, включая президентов».
Журналист считает, что надо смотреть в глаза монстру, чтоб его победить. «То, что «Монсанто» выгнали из России, — пример для остального мира».
К деятельности транснациональной компании «Монсанто» уже давно возникали обоснованные претензии. Ей предъявлялись обвинения биопиратстве и создании угрозы биоразнообразию планеты.
Но в данной ситуации нам стоило бы обратить внимание и на тот аспект, что «Монсанто» занимается и производством широкого спектра продукции военного назначения, в том числе химического оружия и боевых отравляющих веществ. Это к вопросу о том, откуда у украинских нацистов может взяться химическое оружие…
За комментариями по поводу сегодняшних очагов биологических угроз мы обратились к ереванскому общественному деятелю, соучредителю общественно-политического движения «Христианское государство Восточного Айка», лидер коалиции «Единое здоровье» Григору Григоряну.

— Григор, я слышал, что недавний фильм Аркадия Мамонтова «Штамм Андромеда» вызвал бурную реакцию в официальных ереванских СМИ?
— В этом фильме, который показывали по ВГТРК несколько раз в преддверии нового года и уже в наступившем году, я участвовал как эксперт. Рассказывал о ситуации с биологической безопасностью и в частности с медико-биологической деятельностью США в Армении.
То, что этот фильм несколько раз показали, вызвало, мягко говоря, истерию. Я думаю, это вызвало истерию прежде всего в «известном посольстве». И вот по указке этого «известного посольства» был снят на государственном общественном телевидении десятиминутный специальный репортаж про фильм «Штамм Андромеда» и вообще про реакцию РФ на медико-биологическую деятельность США в Армении. Там показывали отрывки из этого фильма. На государственном общественном телевидении прозвучало выражение, дескать, «эта ложь была показана несколько раз». И в очень открытой форме было продемонстрировано возмущение: мол, мы устали уже доказывать РФ, что лаборатории принадлежат нам, что никаких противоправных действий там не ведётся с точки зрения Конвенции по биологическому оружию, но РФ опять на экспертном и на государственном уровне поднимает этот вопрос…
Там выступали эксперты (я с ними работал) и таким, очень взволнованным, тоном объясняли: ничего такого нет, русских специалистов допускали на территорию этой лаборатории, они ничего не нашли. И упор в их доводах был сделан на то, что если все такое противоправное, то почему Россия на государственном уровне поставляет специализированное оборудование?
— Об этих «проверках» и «допусках» Вы уже не раз рассказывали, как это всё происходило на самом деле…
— То, о чем говорят, что, мол, допустили российских специалистов, было в 2017, 2018 гг. И это был чисто ознакомительный визит, насколько я знаю. Это не была инспекция на предмет разработки и накопления компонентов биологического оружия. Если не ошибаюсь, приезжали два микробиолога из Саратова с ознакомительным визитом. Они в помещение лаборатории не входили, никаких инспекций не проводили, никакого анализа и оценки не делали. И отчета об этой деятельности нет. Их просто поводили по коридорам: в Армении народ гостеприимный… Показали здание изнутри, снаружи. И эти люди уехали.
А Российская Федерация много раз настаивала на необходимости прозрачной инспекции, для того чтоб убедиться, что никаких компонентов биологического оружия не разрабатывается и не накапливается. Вот этот простой визит они выдают за инспекцию! Начиная с 2018 года, я неоднократно выступал с пресс-конференцией, говорил, что это чистейшей воды манипуляция. После каждой оценки должен быть отчёт. А этот визит выдают за то, что россияне приезжали и ничего не нашли.

Теперь обратим внимание на то, что происходило после создания ОДКБ комиссии «Биологический щит» и первых специальных подразделений биологической и химической защиты, которые, по некоторым данным, планировали посетить эти лаборатории в этом году, во время учений ОДКБ. Мы увидели, что де факто узурпировавшая власть в нашей стране группировка отказалась проводить учения ОДКБ на нашей территории. И более того, она очень активно толкает нашу страну в объятия НАТО. Буквально на днях занимающий пост премьер-министра встречался с представителем генсека НАТО. Я уже не говорю о встречах с руководителями спецслужб, таких как ЦРУ, МI6.
И с другой стороны, в этом репортаже говорилось, что никакие зарубежные специалисты, в частности из США, сюда не приезжали. Но это чистейшая наглая ложь. По моей информации, как минимум дважды в год эмиссары программы США по разработке биологического оружия приезжали в эту лабораторию.
Вспомним и странные случаи, когда РФ, например, в апреле 2020 г. и июне 2020 г. изъявляла желание войти в эти лаборатории. И сразу же — под видом того, что была утечка, была контаминация, — лаборатории и весь центр резко закрывали на один день, типа для дезинфекции. Но по всем медико-санитарным правилам, контаминация лаборатории, дезинфекция и деконтаминация длятся очень долго. Это не один день. Это недели! А тут резко закрывалась лаборатория. У меня есть серьезные подозрения, что перед визитом российских специалистов спешно вывозилось кое-что из лаборатории. Так было и в случае с Грузией, когда болгарская журналистка Диляна Гайтанджиева отсняла материал о Центре Лугара — и после этого всю ночь там уничтожали документы и т.д.

Я остаюсь при своем мнении, что вот эта сеть лабораторий была и остается единицей медико-биологической разведки США. И если «известное посольство» и курируемое им де факто правительство Армении начали так нервно реагировать, — это свидетельствует о том, что и Российская Федерация, и мы, кто все эти годы поднимали данную проблему, на правильном пути. А там действительно есть что скрывать...
— У кого-то в Армении так пригорает, что понадобилось срочно реагировать на фильм «Штамм Андромеда»?
— Я думаю, что это был хорошо подготовленный выпад в адрес именно РФ. Я все же думаю, что этот репортаж рассчитан на внутреннюю аудиторию. Потому что он был на армянском языке. И у нас есть огромное количество людей, которые имеют допуск только к государственному первому каналу. Это люди, живущие в отдаленных регионах, в приграничных районах, где проблемы с Интернетом, очень плохая связь. И основной канал, который они смотрят, — это первый информационный канал Армении. Он сегодня является рупором режима, захватившего в Армении власть.
Я просто напомню, что это тот канал, который приглашал Навального (в качестве провокации или жеста доброй воли) спикером: дистанционно комментировать ситуацию в РФ. Это было в тот период, когда навальнята организовывали протесты.
В армянской столице все люди с оппозиционными взглядами этот канал, дезинформирующие общественность, не смотрят. На это и было рассчитано. Но мои очень хорошие знакомые нечаянно наткнулись на этот репортаж. Я просмотрел уже в записи и понял, что определенно здесь посыл идёт в адрес РФ. Дескать, Россия возводит напраслину. Дескать, если документ о взаимодействии с Россией уже подписан, то тема уже закрыта, и почему они опять мусолят? Не просто так было подчеркнуто, что фильм ВГТРК — это ложь, показанная по российскому ТВ несколько раз. Это политический посыл. В свете того, что режим, захвативший власть в нашей стране, усиленно и без всяких церемоний уже, без всякой маскировки, толкает Армению в объятия НАТО, отрывая ее от России…
— Для большинства наших читателей понятно, что биологические объекты — это либо угроза, либо абсолютное зло. Но вопрос о рукотворном характере ковида для многих остаётся полемическим.
— Я никогда не разделял аудиторию на тех, кому близко мое мнение или кто не согласен со мной.
Начиная с 2020 года, мы говорили и приводили научные факты относительно того, что любой вирус, если он является зоонозным, должен иметь своего хозяина в дикой природе и т.д. Аксиомы эпидемиологии приводили в пример, доказывали и приводили факты, что эта патология ведёт себя как классическая вирусная болезнь, что возбудитель не найден, хозяин возбудителя в дикой природе не найден. И приводили примеры исследований возбудителя: что было найдено антропогенное вмешательство, в частности со вставками последовательности аминокислот, ДНК и т.д. Это для профильных специалистов и тех, кто понимает, о чём идёт речь.
А для неспециалистов я просто скажу, что сегодня о том, что возбудитель патологии COVID-19 имеет антропогенное происхождение, трубят, в частности, конгрессмены-республиканцы США. Бывший директор Национального института изучения аллергических и инфекционных заболеваний Фаучи сегодня, заикаясь, даёт показания перед судом, что сконструирован возбудитель этой болезни. Это со стороны США мы слышим, не с моей стороны. Если кое-кто относился с недоверием к тому, что мы говорили три года назад, то прошло три года — и уже сами американцы подтверждают.

Недавно обязательная вакцинация против ковида в американской армии была отменена, и все служащие, которые были уволены из-за отказа вакцинироваться, получили право опять вернуться в армию. Столько всех этих нестыковок, что нужно, я думаю, быть или чересчур наивным человеком, или чересчур предвзятым, чтоб под этим буквально вулканом фактов отрицать очевидное, отрицать научно доказанные факты последних двухсот лет и утверждать, что это естественный патоген.
Я уже не говорю о том, что появление новых штаммов напрямую коррелируется с определенными политическими событиями. И поэтому мое дело как специалиста предупредить: это не вопрос веры, это вопрос науки. Если наука имеет свои аксиомы, никто их не может менять. А в вопросе с ковидом получилось так, что тех, кто утверждали, что он естественный, и, брызгая слюной, пытались закрыть рот людям, выражавшим альтернативное мнение, сегодня даже не слышно. Потому что они, трусливо озираясь, сидят по своим углам и думают: не попадет ли им за то, что они защищали ложь, будучи специалистами и прекрасно осознавая, что это ложь. И теперь думают, насколько они разделят ответственность за эту ложь. Потому что если провести беспристрастное расследование по пандемии, то, не исключаю, может получиться так, что международным уголовным судом будет доказано и квалифицировано как преступление против человечества.
Ни один из доводов, приводимых мною, не был основан на каких-то личных умозаключениях. Все доводы имеют научное подтверждение. Я основывался исключительно на том, что говорит наука. Я готов спорить с любым специалистом, независимо от его научного международного звания, квалификации. И поверьте, я докажу. Всё можно найти в книгах и монографиях по эпидемиологии. Это труды блестящих ученых. Взять хотя бы монографии моего старшего российского коллеги Михаила Супотницкого, кандидата биологических наук, полковника медицинской службы в запасе. Это всё имеет свое объяснение и научное обоснование. И читатели могут ознакомиться с теми фактами, которые были опубликованы в последние годы.
— Как считаете, где в ближайшем будущем могут возникнуть очаги беспокойства по части биологических угроз?
— Я думаю, Южная Америка и вообще западное полушарие были полигоном для биологических испытаний до того, как им стали постсоветские страны и страны Юго-Восточной Азии и т.д. Тот же вирус Зика, который вызывает микроцефалию у детей в зародышевой беременности.

Вопрос в другом. Я думаю, что изменится фокус биологической активизации после очевидного успеха и приближения к победе СВО на территории Украины. Центр тяжести сместится в Юго-Восточной Азию, к Монголии, Таиланду… Потому что традиционно наши «заокеанские друзья», ещё после второй мировой войны и в 60-е годы, имели опыт апробации биологических агентов в этих странах. Та же самая Монголия, которая является страной с самой низкой плотностью населения и огромным количеством крупноочаговых инфекций, является идеальным полигоном. И между прочим, при населении всего в 2,5 млн, как например в Армении, она обладает территорией чуть ли не в сто раз большей, чем территория сегодняшней Армении. Плюс несметное количество скота, восприимчивого к самым различным зоонозным инфекциям.
Следует учитывать и их непосредственную близость к Китаю, который является геополитическим соперником США. Я думаю, что именно этот треугольник будет очагом беспокойства, из-за его особенностей, резервуаров, из-за естественных хозяев различных патогенов.
Хотелось бы ещё напомнить, что в 2018 году в Монголии проходила региональная встреча ветеринарных служб Юго-Восточной Азии, во время которой я читал лекцию и говорил о риске заноса вируса африканской чумы свиней на территорию Китая. И в это время наши китайские коллеги заверили, что все необходимые меры предосторожности приняты, чтоб на территорию Юго-Восточной Азии не попал вирус африканской чумы свиней. И буквально через месяц-два после моего выступления была зафиксирована первая вспышка этого заболевания, после чего КНР понесла огромные убытки.
Мои прогнозы не основаны на моих личных доводах. Я отслеживаю информацию, в том числе и научные статьи, которые мониторит коалиция «Единое здоровье». И основываясь на различных источниках, мы анализируем информацию, делаем свои выводы. Исходя из этого, я всё же скажу, что Южная Америка не рассматривается в качестве наиболее вероятного полигона для активизации биологических диверсий. Более вероятно, что это будет территория Евразии, в частности Юго-Восточной Азии.
- Телеграм
- Дзен
- Подписывайтесь на наши каналы и первыми узнавайте о главных новостях и важнейших событиях дня.


Войти через социальные сети: